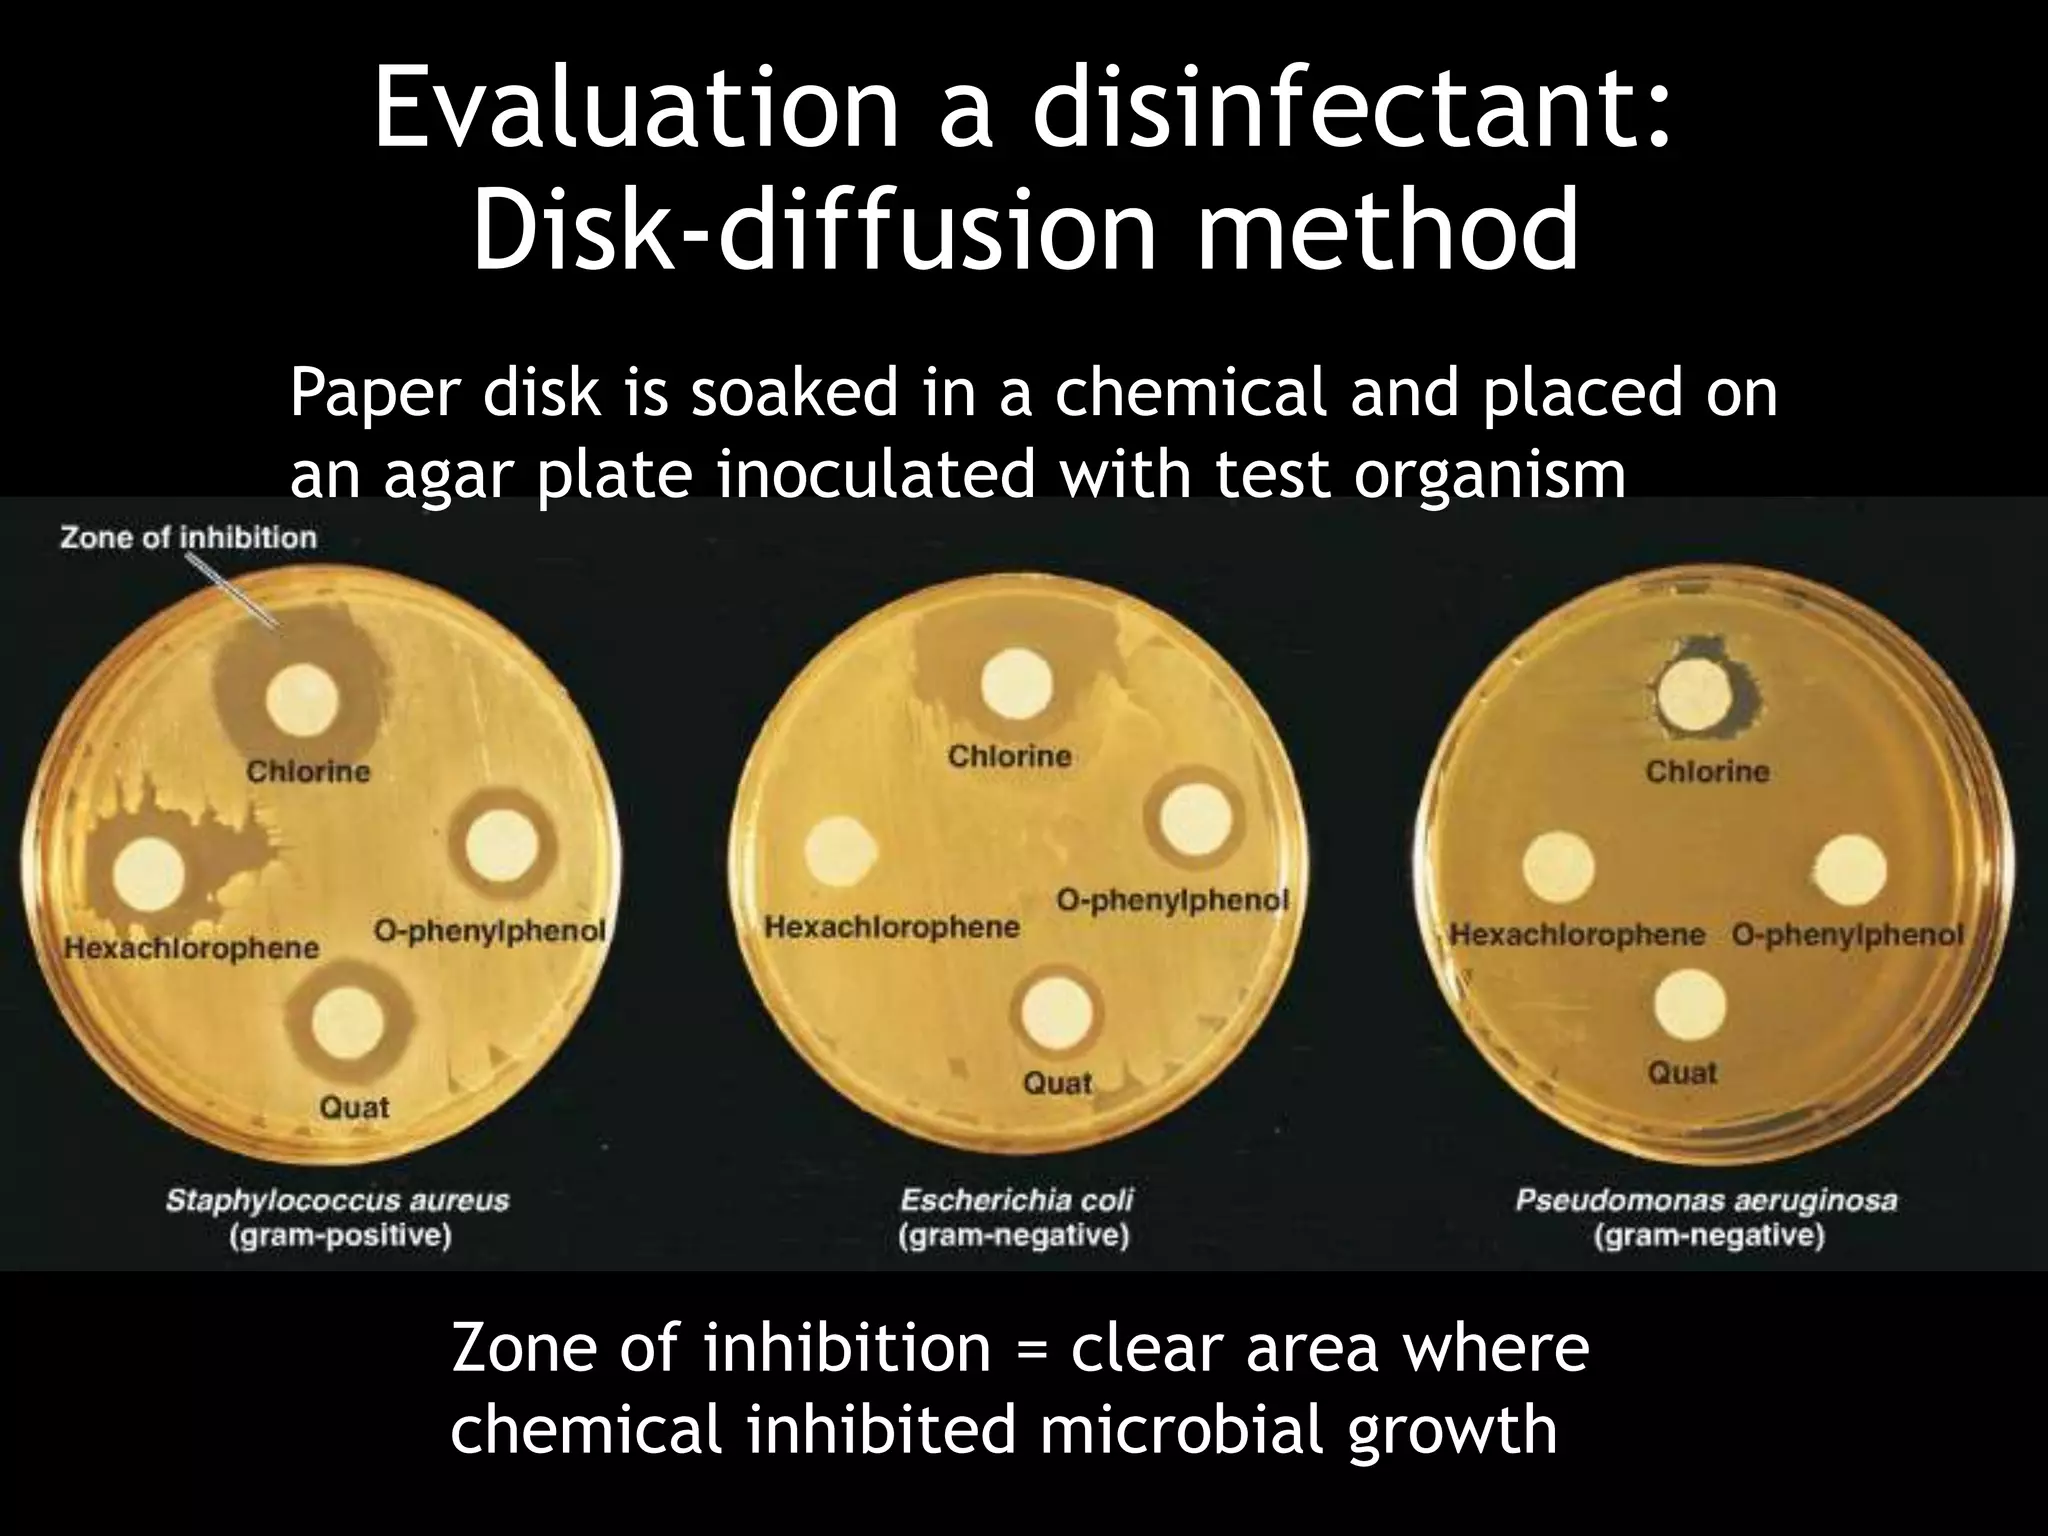
Evaluation a disinfectant:
Disk-diffusion method
Paper disk is soaked in a chemical and placed on
an agar plate inoculated with test organism
Zone of inhibition = clear area where
chemical inhibited microbial growth

This document discusses various methods of controlling microbial growth, including physical and chemical methods. Physical methods covered include heat, filtration, cold, high pressure, dessication, osmotic pressure, and radiation. Chemical methods discussed are phenols, biguanines, halogens (iodine, chlorine), alcohols, heavy metals, surfactants, food preservatives, aldehydes, ethylene oxide, chlorine dioxide, and peroxygens. Specific chemicals are described for each class, along with their antimicrobial mechanisms and common applications.